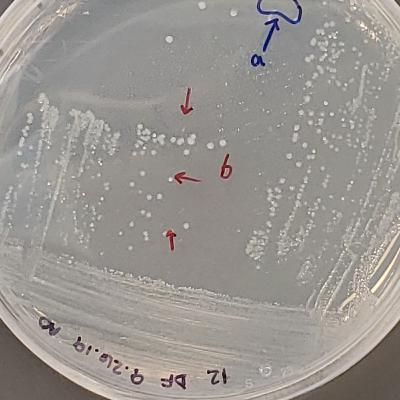
Reorganizing Petri Dish Racks

Discover Lab Sounds ASMR
Lab Sounds ASMR

5 Episodes
Reverse
In this episode I'm cleaning out glassware that had algae growing in it. There are water sounds galore, so if you're a fan of running water or things being filled you are in for a treat. Please let me know if you have any suggestions! Twitter @ihatelightroast
Hello everyone! I'm giving you all an extra episode to make up for not posting anything in a couple weeks. In this episode I'm taking inventory of my bacterial collection. The sounds you'll encounter in this episode are lots of squeaky plastic and rubber noises. There may be short moments of me talking to myself. Hope you enjoy!
I'm extracting DNA from sediment samples from the bottom of Lake Michigan! There are plenty of scraping noises in this episode to get your fix.
In this episode, I'm balancing the pH of an algal culture medium. Enjoy the sounds of gloves squishing against things, running water, glass bouncing gently against glass, and doors gently opening and closing. I talk to myself a few times softly and late into the episode there is some background talking but it is inteligible. You'll also hear the familiar clicking noise of a pipette, and some pen and writing noises as I scribble the details into my lab notebook.
Hear me go about my day in the laboratory! I'm measuring out things for a culture medium. Sounds include: fume hood background, glass and metal tapping noises, sand like sounds, scratching, paper and metal crinkling, scale door opening. Suggestions are welcome!